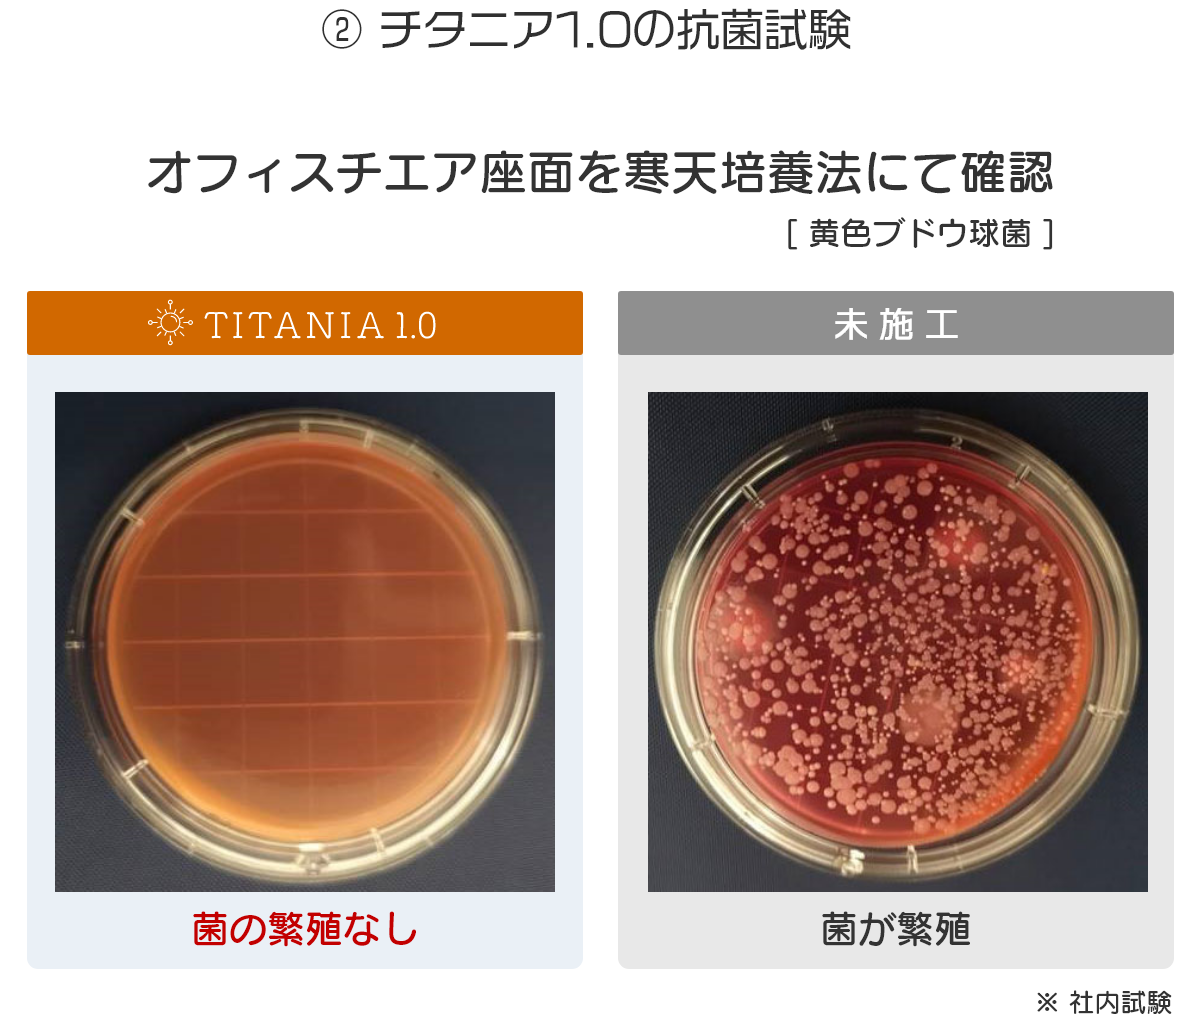
チタニア1.0の抗菌試験

チタニア1.0は「抗ウイルス・除菌・抗菌・消臭」などの効果を持つ光触媒製品です。
チタニア1.0を吹き付けた面に付着した菌やウイルスは、光が当たることにより「継続して無力化」されます。
この「継続する効果」と「人体に無害な成分」であることが、一般的な消毒「アルコール・漂白剤(次亜塩素酸ナトリウム)」などとの大きな違いです。
除菌を行うことが日常となった今、チタニア1.0を使用すれば日々の除菌作業の負担を減らし少しでも楽に、より効果的なウイルス・菌対策が可能です。
また継続して除菌する効果は、様々な人が触れるドアノブや水道の蛇口などにとても効果的です。
チタニア1.0はインフィテック株式会社が開発・製造する光触媒製品です。





チタニア1.0を吹付けた表面は、様々な有機物を強力に分解し「除菌・抗菌・防カビ・消臭」などの効果を発揮します。
太陽光はもちろん、紫外線、蛍光、LED、ブラックライトでも反応し、チタニア1.0が残存する限り常に分解効果を発揮し続けます。
チタニア1.0は、「アルコール・次亜塩素酸ナトリウム」などとは違い無害な成分で作られており、人体にも環境にもやさしい製品です。



吹付けたチタニア1.0は、強力な密着効果で「掃除・水洗い・洗濯」などの日常生活レベルでは簡単に失われることはありません。ご自身で作業されるスプレーボトルタイプでは、1週間から2週間程度の除菌・抗菌効果の継続が見込めます。
※ 人があまり触れない場所は、より長く効果が持続します
2年間の効果を保証する施工です。専門知識を持った専任の技術者により消毒作業と、より密着性の高い業務用チタニア1.0による2層コーティングを施します。
部屋を丸ごとでも、テーブルや椅子のみなど部分的でも、幅広く対応可能です。
※ 施工保証書を発行します


一般的な「アルコール」や「次亜塩素酸ナトリウム」での消毒は、吹付けた瞬間のみの消毒で効果の持続は無く、その都度消毒をしなければいけません。チタニア1.0は、あらかじめ噴霧しておけば、噴霧面に菌やウイルスが付着するたびに無力化し、チタニア1.0の成分が残存する限り継続して効果を発揮します。
チタニア1.0は、菌やウイルスの無力化に最適な濃度(一般的に光触媒と言われているものよりはるかに高濃度)で、独自の技術と製法で粒子が細かく(水溶性酸化チタン)、より確実に菌やウイルスを無力化し、密着性が高く長期間の効果持続に成功した製品です。
※下記「チタニア1.0の様々なデータ」参照
銀イオン・銅イオンを配合しており、光が無い場所でも効果を発揮します。
※ 光の量が多いほど反応効果は上がります
※ 銀・銅イオンを未配合(TITANIA1.0 continue)でも、200ルクス(蛍光灯)程度の光があれば正常に効果を発揮します
(財)日本食品分析センター試験により安全性を確認しており、人体にも環境にも無害な製品です。
銀イオンを含有しておりますが、銀イオンは水銀などとは違い人体に無害なことがWHO により確認・報告されています。


エアコンフィルターに噴霧すれば、フィルターを通るたびに継続的に除菌・抗菌を行うことができ、問題となっているエアコン使用によるクラスターの起こりにくい環境を作ります。
また主成分の酸化チタンは、電子製品の内部などにも使われている素材で、エアコンなどの電化製品に使用しても、金属類を腐食させることが無く不具合や火災を起こす恐れもなく安全です。
チタニア1.0の「除菌・抗菌・消臭・防カビ」効果はエアコンとの相性がとてもよく、エアコンへの使用は多くのメリットがあります。

チタニア1.0は次亜塩素酸ナトリウムなどのような漂白効果や、アルコールのような有機溶剤が含まれていないため素材を傷めることなく安全に使用できます。
日常的にご使用されるものの他、メーカー・販売店様においては、販売前に施工していただければ「除菌・抗菌・消臭・防カビ」の付加価値を与えて販売いただくことも可能です。

チタニア1.0は銀イオン・銅イオンを配合しており、光の少ない棚や下駄箱のような場所でも、確実に効果を発揮します。
※ 銀イオン・銅イオン非配合のスプレーボトルでも、蛍光灯の光(200ルクス)程度で十分な効果を発揮します

チタニア1.0は強固に噴霧面に密着するため、日常のお掃除をいつも通り行う程度であれば、チタニア1.0の効果が簡単に失われることはありません。
水回り全般にご使用いただけます。
※ チタニア1.0を噴霧後、よく乾かしてから水回りをご使用ください

チタニア1.0をマスクに使用すれば、マスク自体に抗ウイルス・除菌・抗菌・消臭などの効果を付与します。また、使い捨てのマスクも通常よりも長期間の使用が見込め、マスクの節約にもつながります。
ハンカチ・タオル・衣類などの身の回りの物にご使用いただけます。

チタニア1.0は「ヘルメット・ジーンズ・帽子・靴・グローブ類・楽器・キャンプ用品・掃除機」など、この他にも様々な 洗えない物への「除菌・抗菌・消臭・防カビ」に最適です。
※ ガラス・プラスチックなどの無機物には密着しにくい場合があります
※ 色の濃い物や撥水性の高い素材への使用は、白く跡が残る場合がありますので必ず適量を守り必要に応じて拭き上げてください





※ 当社試験結果であり、条件により効果が異なる場合があります。